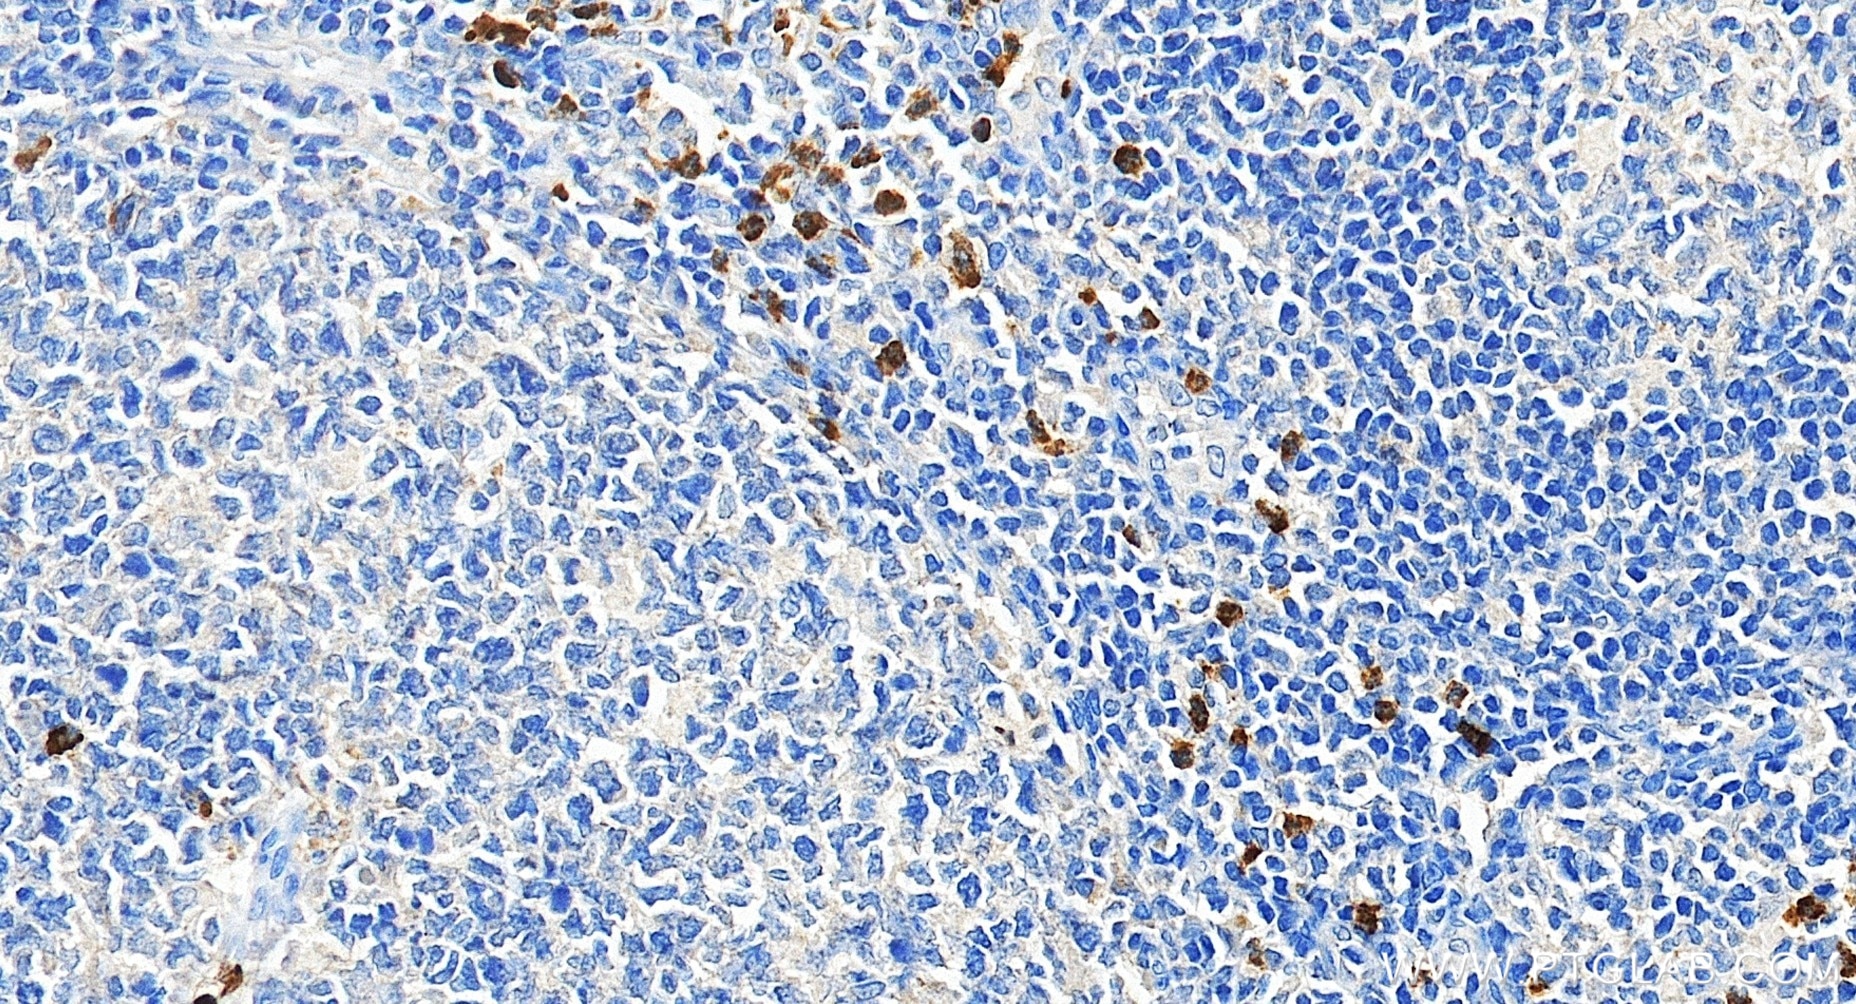
Immunohistochemical analysis of paraffin-embedded human tonsillitis tissue slide using 98616-1-RR (CD15 antibody) at dilution of 1:200 (under 40x lens). Heat mediated antigen retrieval with Tris-EDTA buffer (pH 9.0). This data was developed using the same antibody clone with 98616-1-PBS in a different storage buffer formulation. Immunohistochemistry (IHC) staining of human tonsillitis tissue using Anti-Human CD15 Rabbit Recombinant Antibody (98616-1-RR)

Product Information
98616-1-PBS targets CD15 in IHC, FC applications and shows reactivity with human samples.
| Tested Reactivity | human |
| Host / Isotype | Rabbit / IgG |
| Class | Recombinant |
| Type | Antibody |
| Immunogen |
unknow Predict reactive species |
| Full Name | CD15 |
| Gene Symbol | |
| Gene ID (NCBI) | |
| Conjugate | Unconjugated |
| Form | Liquid |
| Purification Method | Protein A purification |
| Storage Buffer | PBS only, pH 7.3. |
| Storage Conditions | Store at -80°C. |
Background Information
CD15, also known as stage-specific embryonic antigen-1 (SSEA-1) or Lewis X (LeX), is a cell surface glycan consisting of a trisaccharide with the structure Galβ1-4[Fucα1-3]GlcNAc (PMID: 18953356). CD15 is expressed on most terminally differentiated myeloid cells, including neutrophils, eosinophils, monocytes, macrophages, mast cells, and Langerhans cells. It has also been shown to be expressed on stem cells and progenitors in the embryonic and adult nervous system, Hodgkin's lymphoma cells, and cells from a variety of solid cancers (PMID: 19185848). CD15 acts as a ligand for selectins in transendothelial migration and is involved in phagocytosis and chemotaxis (PMID: 1362195).